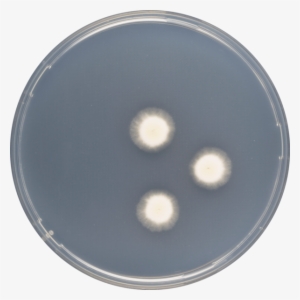
Aspergillus Haitiensis Cya - Circle #1191997

-
Hanukkah Napkin Knot - Circle
450*450
4
1
-
Guitar Pick - - Circle
840*980
2
1
-
Aethetic Saturn Pixel Art - Circle
475*380
7
3
-
Jojo Brandon Coffman - Circle
938*938
3
1
-
Light Distribution Curve - Circle
1380*1471
4
1
-
Circle
1080*844
2
1
-
Circle
1157*317
2
1
-
Png Pdf Svg - Circle
885*883
2
1
-
I Quit The Day Job - Circle
935*921
3
1
-
Fpc Plus - Circle
865*247
4
1
-
Circle
600*600
2
1
-
Aperture Starburst - Circle
800*800
3
1
-
Testimonials - Circle
1067*1067
2
1
-
We Offer Creative Tea Drink Including - Circle
800*800
3
1
-
Td 100 Logo - Circle
552*219
3
1
-
Circle
742*312
2
1
-
Circle
400*400
3
1
-
Pictures, Free Photos, Free Images - Circle
1280*1280
3
1
-
Macaron Prijs Klein - Circle
450*450
3
1
-
Watch-face - Circle
400*400
3
1
-
Author Comments - Circle
379*379
3
1
-
Horseshoe Pin Gold Plated Circa - Circle
530*530
4
1
-
Haddo Awards Luces - Circle
1024*768
4
1
-
Png Destellos Luz - Circle
800*600
5
1
-
Saco Mill - Circle
630*325
3
1
-
Luces - Circle
1450*650
3
1
-
Circle
380*380
2
1
-
Png File - Circle
981*982
2
1
-
Icons For Blocks - Circle
925*197
3
1
-
Y Aca Les Dejo 20 Arcoiris Lindos Png - Circle
496*281
5
1
-
Sunbeam - Registration - Circle
1303*885
3
1
-
Wish List Paw Print - Circle
2500*2500
3
1
-
Slash Boys Hostel - Circle
702*616
3
1
-
Magic Stars, Stardust Fabric - Circle
800*800
5
1
-
Grade - Circle With Diameter Line
604*604
3
1
-
Drawing Paths¶ - Circle
1000*1000
3
1
-
Circle Divided Into
1200*1364
4
1
-
Unit Circle Png
1200*1200
4
1
-
Laundry Fluff & Fold - Circle
1000*1000
4
1
-
Search-icon - Circle
605*605
3
1
-
Searchicon - Circle
455*562
2
1
-
Cropped-hb1 - Circle
628*232
2
1
-
House Icon Blue Circle
401*401
5
1
-
Circle
762*865
3
1
-
Home-target - Circle
1000*1000
3
1
-
Logo Burbujas Disco - Circle
1420*617
2
1
-
Pendulo Barra Disco - Circle
830*860
3
1
-
Round Laminate Top - Circle
656*656
3
1
-
Manchurian Boy Scout Buckle - Circle
442*427
3
1
-
Square To Circle Gif
1500*950
3
1
-
Circle
786*731
2
1
-
Previous - Circle
1000*1000
3
1
-
Transparent Crosshair - Circle
1250*550
4
1
-
Mb Image/png - Circle
800*768
3
1
-
Noncopyright - Circle
800*800
2
1
-
Cd Case - - Circle
980*848
3
1
-
Cd Case Transparent - Circle
500*570
8
3
-
Silver Cd Case Tin - Circle
900*900
3
1
-
Aspergillus Haitiensis Cya - Circle
600*600
2
1
-
Talk-icon - Health Circle Icon
1000*1000
4
1
-
Assistive Technology Icon - Circle
1600*1600
3
1
-
Snowglobe Greeting Card - Circle
700*792
3
1
-
¡gracias Pronto Recibirás Noticias - Circle
743*743
2
1
-
Wine Tasting Preview - Circle
800*800
4
1
-
Shark Fin Theory - Circle
1920*1080
3
1
-
Water Surface - Circle
600*600
3
1
-
131c70 D 3000 3000 S 4 2 - Circle
3000*3000
3
1
-
V2 Cigs Reviews - Circle
500*500
3
1
-
Chips Coupons - Circle
906*848
3
1
-
Water Balance - Circle
663*260
3
1
-
Willy Wonka Graphics - Circle
1920*2485
5
1